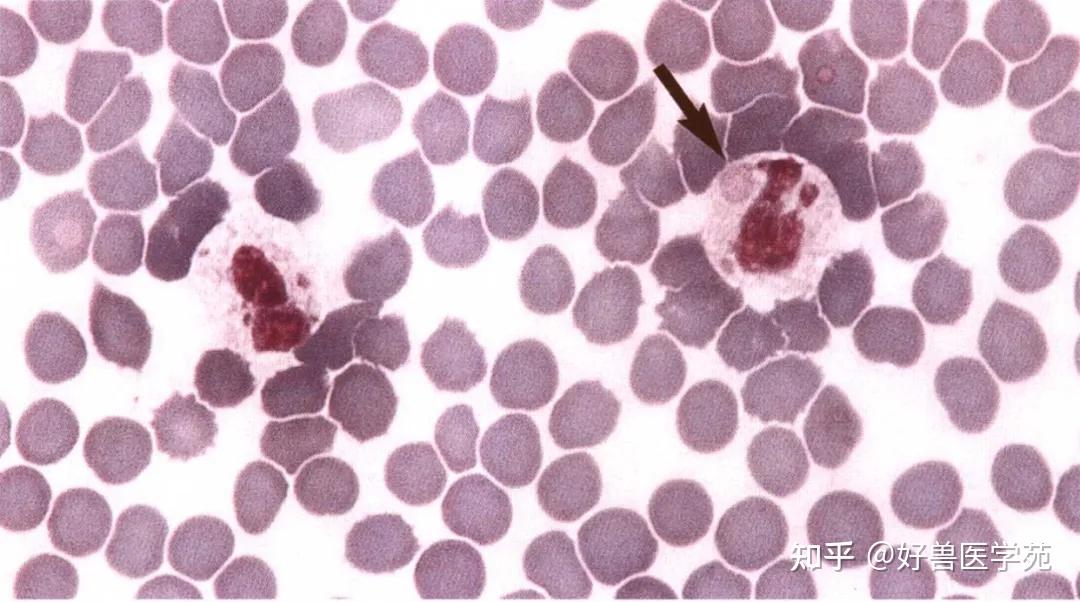
红细胞呈深蓝灰色,这就是无法识别多染色性红细胞.

嗜多染红细胞

97@检验星空92嗜多色性红细胞:多染性红细胞又称嗜多色性红细胞为
图片尺寸1003x1337
嗜多色性红细胞内一个豪焦小体,多见于溶贫,巨幼贫和mds.
图片尺寸1280x1033
▼「嗜多色性红细胞」2020206箭头所指细胞▼「早幼红细胞」2020207
图片尺寸660x481
考虑体内存在感染,并且出现中性粒细胞核左移,镜下有核红细胞,嗜多色
图片尺寸660x674
细胞」形态特征:胞体类圆形;胞质较多,内含大小均一,粉红色的中性颗粒
图片尺寸750x750
2018302箭头所指细胞2【靶形红细胞】▼2018301箭头所指细胞1
图片尺寸706x482
该患者血涂片中可见大量嗜多色性红细胞,见0.
图片尺寸660x495
浆质体vs嗜多色性红细胞
图片尺寸750x563
红细胞多形性
图片尺寸1200x854
172012年第2次血细胞形态学室间质量评价
图片尺寸553x245
犬猫血液学检查技术与判读2--认识红细胞
图片尺寸867x599
形态特征:嗜多色性红细胞是刚刚脱核而未完全成熟的红细胞,体积往往偏
图片尺寸1080x810
嗜碱性点彩红细胞红细胞内可见蓝色小颗粒,大小不等,散在分布,是一种
图片尺寸371x287
嗜点彩红细胞.jpg
图片尺寸440x895
多色是一种障碍那里有血红细胞的数量异常的高
图片尺寸700x695
检查中,若这3个指标异常,别忽视了|红细胞|白细胞|血小板|血液_网易
图片尺寸640x429
图1 外周血涂片中红细胞碎片及嗜多色性红细胞随后急诊医生开外周血
图片尺寸660x495
晚幼红细胞(箭头);没有出现多染性,表明是再生性贫血.
图片尺寸720x406
嗜酸性粒细胞比例增高,可见2%原始细胞(图2,3);红细胞大小不
图片尺寸660x495
红细胞呈深蓝灰色,这就是无法识别多染色性红细胞.
图片尺寸1080x602